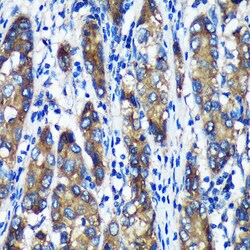

Learn More
Invitrogen™ TXNDC12 Polyclonal Antibody


Description
Positive test controls include: U-251MG, 293T, HepG2, Mouse brain, Mouse heart, Mouse kidney. The target is usually found in the following locations: Endoplasmic reticulum lumen. Immunogen sequence: NLEDEEEPKD EDFSPDGGYI PRILFLDPSG KVHPEIINEN GNPSYKYFYV SAEQVVQGMK EAQERLTGDA FRKKHLEDEL.

Specifications
Specifications
| Antigen | TXNDC12 |
| Applications | ELISA, Immunohistochemistry (Paraffin), Western Blot, Immunocytochemistry |
| Classification | Polyclonal |
| Concentration | 2.21 mg/mL |
| Conjugate | Unconjugated |
| Formulation | PBS with 50% glycerol and 0.01% thimerosal; pH 7.3 |
| Gene | Txndc12 |
| Gene Accession No. | O95881, Q498E0, Q9CQU0 |
| Gene Alias | 0610040B21Rik; AG1; AGR1; anterior gradient homolog 1; endoplasmic reticulum protein ERp19; endoplasmic reticulum resident protein 18; Endoplasmic reticulum resident protein 19; endoplasmic reticulum thioredoxin superfamily member, 18 kDa; ER protein 18; ER protein 19; ERp16; ERP18; ERP19; hAG-1; hTLP19; ortholog of endoplasmic reticulum thioredoxin superfamily member, 18 kDa TLP19; PDIA16; protein disulfide isomerase family A, member 16; RGD1305960; thioredoxin domain containing 12; thioredoxin domain containing 12 (endoplasmic reticulum); thioredoxin domain-containing protein 12; Thioredoxin-like protein p19; TLP19; TXNDC12; UNQ713/PRO1376 |
| Gene Symbols | Txndc12 |
| Show More |
By clicking Submit, you acknowledge that you may be contacted by Fisher Scientific in regards to the feedback you have provided in this form. We will not share your information for any other purposes. All contact information provided shall also be maintained in accordance with our Privacy Policy.